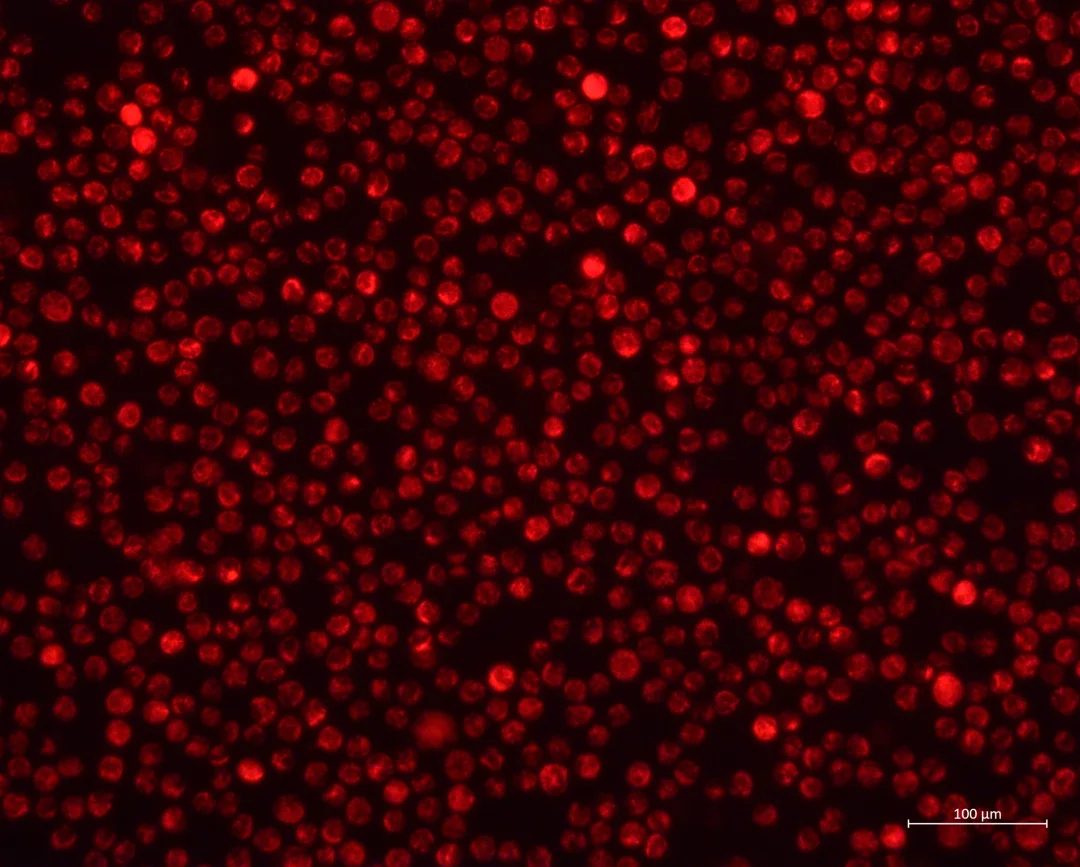

任兴趣学 任性去学 游学团
膜电位是常见的线粒体功能检测指标,之前也总结过所有的线粒体功能实验,可以🔍去看哦
常见的测膜电位的试剂:TMRM,TMRE,JC-1
TMRM和TMRE类似,阳离子荧光染料
[向右R]在正常细胞中进入线粒体基质发出红色荧光(肉眼看会有些桔红色)
[向右R]当细胞受损(例如凋亡)线粒体膜电位下降,细胞内荧光消失
[向右R]也就是膜电位下降,视野内红色荧光减少!
[向右R]JC-1也属于阳离子荧光染料,正常细胞内发出红色荧光,线粒体受损时膜电位下降或丧失,JC-1只能以单体的形式存在于胞浆中,发出绿色荧光
[向右R]也就是膜电位下降:视野内会出现绿色荧光!
个人比较喜欢用的是TMRE(如图),做实验的感受基本是膜电位丧失(红色荧光消失),很少见到膜电位下降的情况(红色荧光减弱)❗️
可以用荧光显微镜拍摄,也可染色后做流式分析~因为本人要merge白光视野中的细胞图(mark一下死细胞膜电位丧失这一点),所以采用🔬拍摄,可视化强一点,很直观
图上可以明显看到发生焦亡的细胞,红色荧光消失
染色方法:
1、TMRE 配制成1*工作液(一般试剂都会自带缓冲液配制工作液),6孔板可以配置1ml备用
2、悬浮细胞取50~100万,密度刚好,离心,用1ml工作液重悬放到6孔板中
3、37度培养箱孵育15~45min,我一般孵育20min,孵育太久容易背景高
4、到时间后,拿出细胞到荧光显微镜下检查是否染上(注意避光),如果染上了就可以去洗细胞,用pbs洗
⚠️注意1:贴壁细胞弃掉上清,用pbs轻轻润洗即可,悬浮细胞离心然后pbs轻柔重悬洗一次,可以用600g*5min去离心
⚠️注意2:
如果用TMRE或者TMRM染色,必须拍和细胞的merge图,这样才能证明膜电位下降,否则只有荧光图无法证明
如果用JC-1染色,merge不是必须的,因为出现绿色荧光即代表膜电位下降or丧失
⚠️注意3:
拍摄merge图,本人是不洗细胞的(尤其悬浮,不要洗),因为洗细胞会丢失很多受损的细胞,会降低阳性率,染色完以后,直接拿去荧光显微镜拍摄即可❗️🔬
染色只要不要太久,背景不高,不用担心背景问题
科研日常 细胞实验 研究生 研究生日常 科研 线粒体膜电位 科研学习